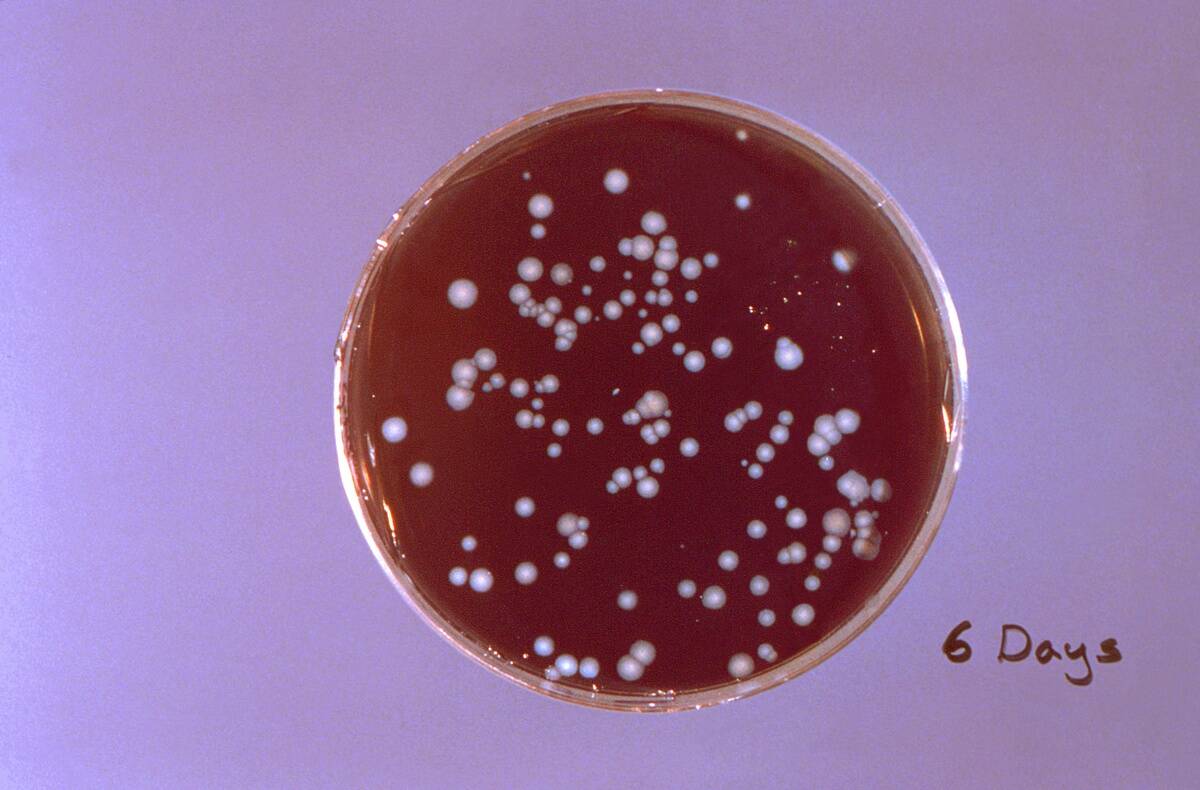
Legionella Pneumophila

Facts about animals that cultivate their own food
Trending Now
When we think of farming, we often imagine fields of crops tended by humans. However, the animal kingdom boasts its own impressive roster of agricultural experts. From tiny insects to clever marine creatures, these animal farmers have developed intricate methods to cultivate their food.
By examining their skills, we gain insight into nature’s ingenuity and the surprising parallels to human agriculture. These natural farmers not only showcase adaptability but also highlight the complex relationships between species and their environments.
The Leafcutter Ants: Masters of Fungus Farming

Leafcutter ants are known for their remarkable ability to farm fungus, a practice they have honed for millions of years. These industrious insects cut leaves and transport them back to their colonies, where the leaves serve as a substrate for their fungus gardens.
The ants carefully tend to these gardens, which provide their primary food source. This mutualistic relationship is a classic example of how cooperation benefits both the ants and the fungi, enabling them to thrive together in a symbiotic ecosystem.
The Ingenious Techniques of Attine Ants

Attine ants, a subgroup of fungus-farming ants, have evolved sophisticated techniques to cultivate their crops. They meticulously clean their gardens of pests and debris, ensuring optimal growing conditions for the fungi.
Additionally, these ants have been observed using antimicrobial secretions to protect their crops from harmful pathogens. This level of agricultural acumen rivals human farming practices, highlighting the complexity and evolutionary success of these tiny cultivators. Their ability to maintain such a refined system is a testament to their adaptability.
Termites: The Unsung Farmers of the Insect World

Termites are often associated with destruction, but they also play a vital role as natural farmers. Certain termite species cultivate fungus inside their nests, which they use as a food source. This farming practice involves creating specialized chambers and carefully managing moisture levels, demonstrating their impressive engineering skills.
By breaking down tough plant material into a digestible form, termites contribute to nutrient cycling in their ecosystems. Their role as decomposers and farmers is integral to maintaining ecological balance.
How Dung Beetles Cultivate Their Own Food

Dung beetles are best known for burying and shaping dung into brood balls for feeding their larvae. In some species, beetles condition these brood balls by introducing or encouraging microbial growth (including fungi and bacteria), which helps break down dung and improve its nutritional value for developing larvae.
This behavior described as microbial conditioning, enhances digestion and nutrient availability. By burying dung and supporting decomposition, dung beetles significantly improve soil structure, nutrient cycling, and ecosystem health.
Ambrosia Beetles and Their Symbiotic Fungal Gardens

Ambrosia beetles have developed a fascinating relationship with fungi, which they farm inside the tunnels they bore into trees. These beetles carry fungal spores in specialized structures and inoculate them within the wood, cultivating their gardens.
The fungi break down the wood, providing nourishment for the beetles and their larvae. This symbiotic relationship allows ambrosia beetles to thrive in environments where food sources are otherwise scarce. Their farming techniques are a testament to the intricate connections in nature.
The Farming Methods of the Southern Pine Beetle

The southern pine beetle is notorious for its destructive impact on forests, but it also showcases intriguing farming behaviors. These beetles carry fungi in specialized pockets and introduce them to pine trees, where the fungi help break down the tree’s defenses.
This not only provides a food source for the beetles but also aids in overcoming the tree’s natural defenses. This partnership exemplifies a complex ecological interaction, where the beetles and fungi both benefit, albeit at the expense of the host tree.
The Fascinating World of Marine Farmers: Damselfish and Their Algae Crops

In the marine world, damselfish are well-known for their farming prowess, particularly their cultivation of algae. These small fish fiercely defend patches of algae on coral reefs, ensuring a steady food supply by weeding out unwanted species and promoting the growth of preferred algae.
Through this meticulous gardening, damselfish maintain a balance within their chosen patches, impacting the surrounding marine ecosystem. Their farming activities demonstrate the intricate relationships between marine species and the environment they inhabit.
How Certain Crab Species Harvest Seaweed

Certain crab species, like the decorator crab, are adept at ‘farming’ seaweed. They strategically attach seaweed to their shells, not only as camouflage but also as a food source. By selecting specific types of seaweed, they can cultivate their own portable farms, which serve as both sustenance and protection.
This dual-purpose farming technique highlights the resourcefulness of these crabs, showcasing how animal farmers can creatively adapt their environments to meet their needs in various ways.
The Unique Farming Habits of Acromyrmex Ants

Acromyrmex ants, closely related to leafcutters, also engage in fungus farming with a few unique twists. They are known for their ability to cultivate fungal strains, which offers a diversified diet and reduces the risk of crop failure.
By maintaining a variety of fungi, Acromyrmex ants increase their resilience against environmental changes. This strategy mirrors human agricultural practices, where crop diversity is key to food security and sustainability. Their farming methods underscore the adaptability of these industrious ants.
Understanding the Relation Between Fungus-Farming and Ant Evolution

The evolution of fungus-farming ants is a fascinating tale of symbiosis and adaptation. These ants have co-evolved with their fungal partners over millions of years, developing specialized behaviors and physical traits to enhance their farming success.
This long-term relationship has resulted in significant evolutionary changes, such as the development of complex social structures and division of labor within colonies. Studying these evolutionary adaptations provides insights into the dynamics of mutualistic relationships and the co-evolutionary processes that shape them.
The Role of Bacteria in Animal Farming Ecosystems
Bacteria play a crucial role in the farming ecosystems of many animal farmers, acting as helpers in breaking down organic material or protecting crops from pathogens. In the case of leafcutter ants, specific bacteria produce antibiotics that help keep their fungal gardens free from harmful microbes.
This tripartite relationship between ants, fungi, and bacteria showcases the complexity and interdependence within these ecosystems. Understanding the role of bacteria can reveal how microbial allies contribute to the success of animal farming practices.
The Surprising Agricultural Practices of the Marsh Periwinkle Snail

The marsh periwinkle snail exhibits a surprisingly sophisticated form of farming. By grazing on marsh grass and creating wounds, these snails encourage fungal growth, which they then consume. This indirect farming practice enhances the nutritional value of their food, illustrating a unique strategy for maximizing resources in their habitat.
The marsh periwinkle’s behavior exemplifies how seemingly simple creatures can engage in complex ecological interactions, contributing to the diversity of farming practices observed in the animal kingdom.
Lessons From Nature: What Humans Can Learn From Animal Farmers

Animal farmers offer valuable lessons in sustainability, resource management, and symbiotic relationships. Observing these natural agricultural systems can inspire innovative solutions to human agricultural challenges, such as pest control and crop diversity. For instance, the mutualistic partnerships observed in fungus-farming ants highlight the benefits of biodiversity and cooperation.
By emulating these strategies, humans can improve agricultural practices and develop more sustainable systems that work in harmony with nature, fostering a deeper understanding of ecological balance.
The Environmental Impact of Animal Farming in the Wild

Animal farming in the wild, while often beneficial to ecosystems, can also have unintended environmental impacts. For example, the aggressive farming of damselfish can lead to localized changes in coral reef composition. Similarly, the burrowing activities of ambrosia beetles can damage trees, affecting forest health.
These examples demonstrate the delicate balance between agricultural practices and ecosystem health. Understanding and mitigating these impacts is crucial for preserving biodiversity and maintaining the intricate web of life in natural habitats.
How Climate Change Affects Animal Farming Practices

Climate change poses significant challenges to animal farming practices, as shifting environmental conditions can disrupt established relationships. For example, changes in temperature and humidity can affect the growth of fungal crops, impacting the food supply for ants and beetles.
Additionally, rising sea levels and ocean acidification threaten marine farmers, such as damselfish and crabs. These changes highlight the need for adaptability and resilience in natural farming systems, emphasizing the importance of understanding and mitigating the effects of climate change on these practices.
Fun Facts About Animal Farmers: Did You Know?

Did you know that leafcutter ants can carry up to 10-20 times their body weight while transporting leaves to their colonies? Or that certain damselfish species are so protective of their algae gardens that they will fiercely chase away intruders many times their size?
These fun facts highlight the surprising capabilities and behaviors of animal farmers, showcasing the diversity and creativity found in nature. The more we learn about these incredible creatures, the more we appreciate the complexity and ingenuity of life on our planet.




